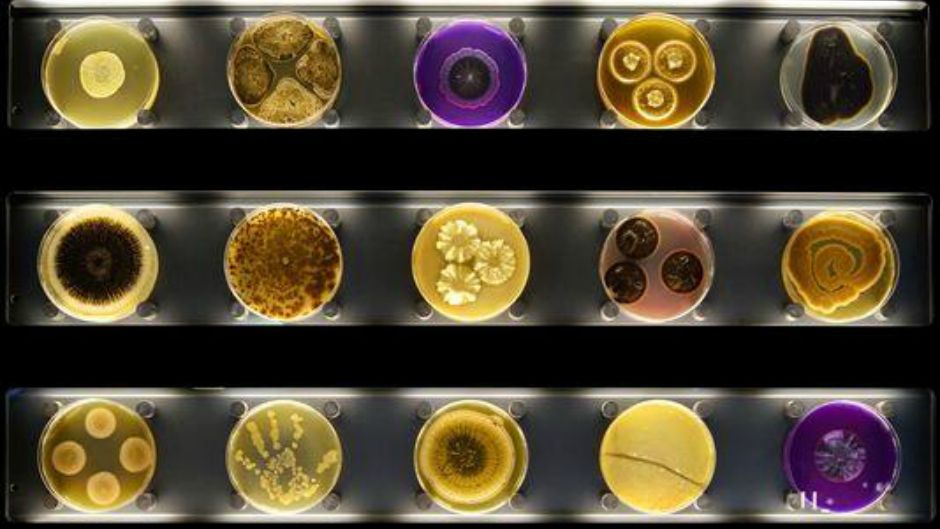
mikrobi tw

Prvi "interaktivni zoološki vrt mikroba" na svijetu otvoren je u utorak u Amsterdamu i upoznaje posjetitelje sa životom minijaturnih bića koja čine dvije trećine živog svijeta i presudni su za budućnost života na Zemlji.
"Zoološki vrtovi tradicionalno prikazuju samo mali dio prirode i to uglavnom velike životinje", kazao je direktor zoološkog vrta Artis Haig Balian koji je osmislio ideju Micropia muzeja, vrijednog 10 miliona eura, prije 12 godina.
"Danas želimo predstaviti mikro-prirodu", kazao je Balian koji vjeruje da je važnost mikroba u svakodnevnom životu zanemarena još od 17. stoljeća kada ih je holandski naučnik Antonie van Leeuwenhoek prvi puta uočio pod mikroskopom.
Mikrobi asociraju na bolesti, no bakterije, virusi, gljivice i alge ključni su u održavanju života na Zemlji, kaže Balian.
"Mikrobi su svagdje. Mikrobiolozi mogu raditi u svakom sektoru od bolnica i proizvodnje hrane, preko naftne industrije do farmaceutske industrije", kaže Balian koji vjeruje da bi muzej mogao pobuditi interes za mikrobiologijom.
Mikrobi se koristi u proizvodnji biogoriva, stvaranju novih antibiotika ili poboljšavanju poljoprivrednih prinosa a istraživanja pokazuju da imaju široki potencijal od stvaranja struje preko jačanja temelja građevina do liječenja karcinoma.
Svaki čovjek nosi prosječno oko 1,5 kilograma mikroba i bez njih bi umro.
Veći dio muzeja izgleda poput laboratorija s redovima mikroskopa povezanima s velikim televizijskim ekranima. Posjetitelji, kao u pravom laboratoriju, mogu kroz prozore gledati kako se razne vrste mirkoba množe u Petrijevim zdjelicama i testnim cijevima.
Skener za mikrobe pokazat će koliko mikroba živi na koži posjetitelja.
"Znate li da, primjerice, oko 700 vrsta mikroba živi u vašim ustima? Ili 80 vrsta gljivica na vašim petama?" pita Balian.
Kakvo je tvoje mišljenje o ovome?
Učestvuj u diskusiji ili pročitaj komentare
Kakvo je tvoje mišljenje o ovome?
Učestvuj u diskusiji ili pročitaj komentare





 Srbija
Srbija
 Hrvatska
Hrvatska
 Slovenija
Slovenija


























































